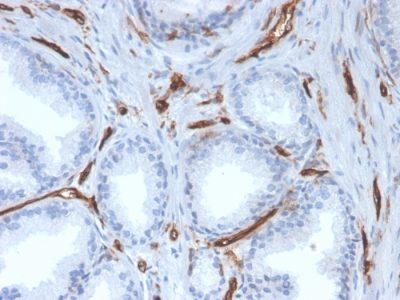
CD31 / PECAM-1 Monoclonal Mouse Antibody (PECAM1/3527)

CD31 / PECAM-1 Monoclonal Mouse Antibody (PECAM1/3527)
CONJUGATION
CD31 (PECAM-1) 是粘附分子免疫球蛋白超基因家族的跨膜糖蛋白成员。CD31 由造血系统的干细胞表达,主要用于鉴定和浓缩这些细胞以进行实验研究和骨髓移植。已显示抗 CD31 对血管内皮细胞具有高度特异性和敏感性。非血管肿瘤(不包括造血肿瘤)的染色很少见。CD31 MAb 与构成血管内层的正常、良性和恶性内皮细胞发生反应。CD31 表达水平可以帮助确定肿瘤血管生成的程度,而高水平的 CD31 表达可能意味着快速生长的肿瘤和潜在的肿瘤复发的预测因子。
一抗可提供纯化的,或带有荧光 CF® 染料和其他标记的选择。CF® 染料具有出色的亮度和光稳定性。有关更多信息,请参阅CF® 染料手册。注意:不推荐使用 CF®405S 和 CF®405M 等蓝色荧光染料的偶联物检测低丰度目标,因为蓝色染料的荧光较低,并且比其他染料颜色可以产生更高的非特异性背景。
库存状态:由于 Biotium 提供大量抗体和偶联选择,因此可以订购一抗偶联物。CF® 染料和生物素偶联物的典型交货时间最长为 1 周,荧光蛋白和酶偶联物的交货时间最长为 2-3 周。
一抗偶联物的目录编号键
| 抗体#前缀 | 共轭 | 防爆/电磁 (nm) | 激光线 | 检测通道 | 染料特性 |
|---|---|---|---|---|---|
| BNC04 | CF®405S | 404/431 | 405 | DAPI(显微镜),AF405 | CF®405S 特点 |
| BNC88 | CF®488A | 490/515 | 488 | GFP, FITC | CF®488A 特点 |
| BNC68 | CF®568 | 562/583 | 532, 561 | RFP,TRITC | CF®568 特点 |
| BNC94 | CF®594 | 593/614 | 561 | Texas Red | CF®594 特点 |
| BNC40 | CF®640R | 642/662 | 633-640 | Cy®5 | CF®640R 特点 |
| BNC47 | CF®647 | 650/665 | 633-640 | Cy®5 | CF®647 特点 |
| BNCB | Biotin | N/A | N/A | N/A | |
| BNUB | Purified | N/A | N/A | N/A | |
| BNUM | Purified, BSA-free | N/A | N/A | N/A |
Alexa Fluor、Pacific Blue、Pacific Orange 和 Texas Red 是 Thermo Fisher Scientific 的商标或注册商标;Cy 是 GE Healthcare 的注册商标;IRDye、LI-COR 和 Odyssey 是 LI-COR Bioscience 的注册商标。
产品推荐
TrueBlack® Lipofuscin Autofluorescence Quencher
产品编号:
23007
详细视图
Paraformaldehyde, 4% in PBS, Ready-to-Use Fixative
产品编号:
22023
详细视图
EverBrite™ Mounting Medium
产品编号:
23002
- 23001
详细视图
CoverGrip™ Coverslip Sealant
产品编号:
23005
- 23005-1
详细视图
RedDot™2 Far-Red Nuclear Stain, 200X in DMSO
产品编号:
40061-T
- 40061-1
查看全部
详细视图
AntiFix™ Universal Antigen Retrieval Buffer, 10X
产品编号:
22030-50mL
- 22030-500mL
详细视图